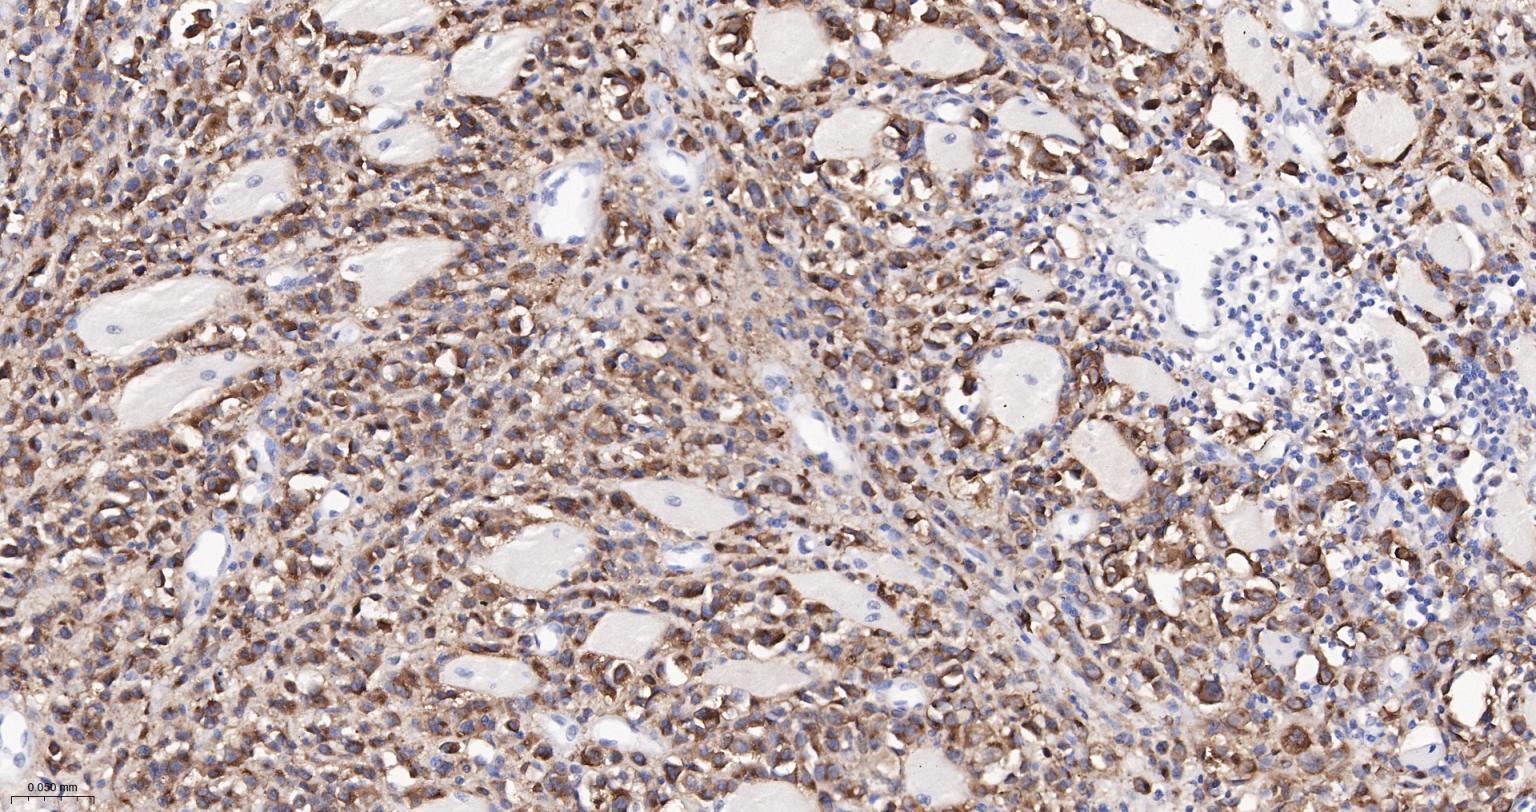
黑色素瘤相关抗原gp100重组兔单抗

黑色素瘤相关抗原gp100重组兔单抗
Rrmab?兔单抗

货号:bsm-61122R
产品详情
相关标记
相关产品
相关文献
常见问题
概述
产品编号
bsm-61122R
产品类型
重组兔单抗、mIHC精品抗体
英文名称
PMEL Recombinant Rabbit mAb
中文名称
黑色素瘤相关抗原gp100重组兔单抗
英文别名
D12S53E; HMB-45; HMB45; ME20; ME20-M; ME20M; P1; P100; PMEL17; SI; SIL; SILV; gp100; D10H12S53E; D12S53Eh; gp87; PMEL_BOVIN; PMEL; Melanocyte protein Pmel 17; Premelanosome protein; Retinal pigment epithelial-specific protein; Silver locus protein homolog; RPE1; PMEL_HUMAN; ME20-M (ME20M); Melanocytes lineage-specific antigen GP100; Melanoma-associated ME20 antigen; PMEL_MOUSE; Silver locus protein;
抗体来源
Rabbit
免疫原
A synthesized peptide derived from human PMEL: 600-661/661
亚型
IgG
性状
Liquid
纯化方法
affinity purified by Protein A
克隆类型
Recombinant
克隆号
11E7
理论分子量
70 kDa
检测分子量
95 kDa
储存液
10mM phosphate buffered saline(pH 7.4) with 150mM sodium chloride, 0.05% BSA, 0.02% Proclin300 and 50% glycerol.
研究领域
SWISS
Gene ID
保存条件
Store at 4℃ for short term. Store at -20℃ for long term. Avoid repeated freeze/thaw cycles.
注意事项
This product as supplied is intended for research use only, not for use in human, therapeutic or diagnostic applications.
数据库链接
背景资料
Plays a central role in the biogenesis of melanosomes. Involved in the maturation of melanosomes from stage I to II. The transition from stage I melanosomes to stage II melanosomes involves an elongation of the vesicle, and the appearance within of distinct fibrillar structures. Release of the soluble form, ME20-S, could protect tumor cells from antibody mediated immunity.

产品应用
| 应用 | 已检合格种属 | 预测种属 | 推荐稀释比例 |
|---|---|---|---|
| WB | Human | 1:500-2000 | |
| IHC-P | Human | 1:200-800 | |
| IHC-F | Human | 1:200-800 | |
| IF | Human | 1:200-800 |
交叉反应
交叉反应: Human
相关产品
暂无相关产品
靶标
基因名
PMEL
蛋白名
Melanocyte protein PMEL
亚细胞定位
Secreted and Endoplasmic reticulum membrane. Golgi apparatus. Melanosome. Endosome > multivesicular body. Identified by mass spectrometry in melanosome fractions from stage I to stage IV. Localizes predominantly to intralumenal vesicles (ILVs) within multivesicular bodies. Associates with ILVs found within the lumen of premelanosomes and melanosomes and particularly in compartments that serve as precursors to the striated stage II premelanosomes.Target information above from: UniProt accession P40967 The UniProt Consortium
The Universal Protein Resource (UniProt) in 2010
Nucleic Acids Res. 38:D142-D148 (2010) .
组织特异性
Preferentially expressed in melanomas. Some expression was found in dysplastic nevi. Not found in normal tissues nor in carcinomas. Normally expressed at low levels in quiescent adult melanocytes but overexpressed by proliferating neonatal melanocytes and during tumor growth.
翻译后修饰
A small amount of P1/P100 (major form) undergoes glycosylation to yield P2/P120 (minor form). P2 is cleaved by a furin-like proprotein convertase (PC) in a pH-dependent manner in a post-Golgi, prelysosomal compartment into two disulfide-linked subunits: a large lumenal subunit, M-alpha/ME20-S, and an integral membrane subunit, M-beta. Despite cleavage, only a small fraction of M-alpha is secreted, whereas most M-alpha and M-beta remain associated with each other intracellularly. M-alpha is further processed to M-alpha N and M-alpha C. M-alpha C further undergoes processing to yield M-alpha C1 and M-alpha C3 (M-alpha C2 in the case of PMEL17-is or PMEL17-ls). Formation of intralumenal fibrils in the melanosomes requires the formation of M-alpha that becomes incorporated into the fibrils. Stage II melanosomes harbor only Golgi-modified Pmel17 fragments that are derived from M-alpha and that bear sialylated O-linked oligosaccharides.
N-glycosylated. O-glycosylated; contains sialic acid.
N-glycosylated. O-glycosylated; contains sialic acid.
相似性
Belongs to the PMEL/NMB family.
Contains 1 PKD domain.
Contains 1 PKD domain.
功能
Plays a central role in the biogenesis of melanosomes. Involved in the maturation of melanosomes from stage I to II. The transition from stage I melanosomes to stage II melanosomes involves an elongation of the vesicle, and the appearance within of distinct fibrillar structures. Release of the soluble form, ME20-S, could protect tumor cells from antibody mediated immunity.
标记抗体
暂无标记数据
同靶标产品
暂无同靶标产品
相关文献
提示: 发表研究结果有使用 bsm-61122R 时请让我们知道,以便我们可以引用参考文章。作为回馈,资料提供者将获得我们送上的小礼品。
具体参考文献:bsm-61122R 被引用于1文献中
暂无相关文献
常见问题
暂无常见问题